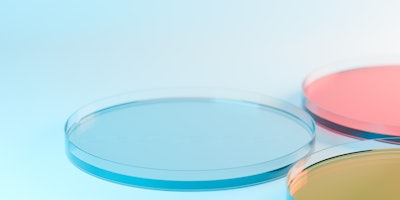
In an era of consumer demands for efficacy, getting clinical testing right is critical. Especially for OTC products.

Consumers want sun care, but their preferences are shifting radically, signaling significant opportunities for brands to tap into the sunification of beauty. Here’s what the data tells us and how brands and emerging ingredient technologies offer a path forward to capture market share.
This article is only available to registered users.
Log In to View the Full Article
Consumers want sun care, but their preferences are shifting radically, signaling significant opportunities for brands to tap into the sunification of beauty. Here’s what the data tells us and how brands and emerging ingredient technologies offer a path forward to capture market share.
What Consumers Are Looking for From SPF Beauty
A July 2024 study by behavioral insights platform Veylinx recently founda that just 30% of the 1,609 U.S. consumers surveyed apply sunscreen daily during summer, while just 27% use sunscreen year-round.
 A recent report points out that almost 75% of consumers “prefer using tinted foundation with sun protection.” This is backed up by a July 2024 Trendalytics report pointing out that tinted SPF searches are up 84% year-over-year, while searches for SPF foundations are up 23%.mellisandra at Adobe Stock
A recent report points out that almost 75% of consumers “prefer using tinted foundation with sun protection.” This is backed up by a July 2024 Trendalytics report pointing out that tinted SPF searches are up 84% year-over-year, while searches for SPF foundations are up 23%.mellisandra at Adobe Stock
The report also points out that almost 75% “prefer using tinted foundation with sun protection.” This is backed up by a July 2024 Trendalytics reportb pointing out that tinted SPF searches are up 84% year-over-year, while searches for SPF foundations are up 23%.
Data from a Spate x Symrise report from May 2024 notes that top search terms associated with tinted foundations included “oily skin,” “mature skin” and “aging.” Separately, a June 2024 report from Spate pointed out that tinted sunscreen searches have benefited the brand Alsastin, which markets SKUs such as the HydraTint Pro Mineral Broad Spectrum Sunscreen SPF 36 and has experienced a more than 100% year-over-year jump in U.S. online searches.
Reflecting this trend toward tinted hybrid products, Lubrizol recently developed a range of hybrid sun care products, including a tinted SPF moisturizer, a lightweight, all-mineral sunscreen with UVA and UVB protection.
Veylinx’s report notes an uptick in demand for SPF products with hydrating benefits, while Trendalytics reports that SPF moisturizer searches are up 22% year-over-year.
Other key claims cited by the two reports include a demand for:
- Clear formulations with no white cast
- Reef-safe claims (shoppers are willing to pay 14% more for such products)
- Formats such as serums and lip balms
- SPF plus anti-aging benefits (related: the Veylinx report highlighted a high desire for formulations comprising vitamin C)
- K-beauty inspiration, per a June 2024 report, as seen with a more than 420% jump in U.S. online searches for “Tocobo sunscreen stick,” referencing a K-beauty brand that offers SPF beauty in a convenient format
SPF Beauty Trends in Action: Freaks of Nature
 Surfer Kelly Slater has launched a direct-to-consumer skin care brand, Freaks of Nature, that encompasses so many of the concerns and trends surfaced in data cited by Spate, Trendalytics and Veylinx.Freaks of Nature
Surfer Kelly Slater has launched a direct-to-consumer skin care brand, Freaks of Nature, that encompasses so many of the concerns and trends surfaced in data cited by Spate, Trendalytics and Veylinx.Freaks of Nature
The brand was spawned in cooperation with investment and incubation firm Squared Circles company, which previously collaborated with brands such as Nutrafol and Phyla Biotics. Additional investors in Freaks of Nature include Mike Meldman, co-founder of Casamigos tequila and founder of Discovery Land, and actor and filmmaker Jonah Hill.
(Squared Circles itself is backed by L Catterton, Regeneration.VC and David Bonderman.)
The new brand is designed for “outdoor enthusiasts + athletes,” per Freaks of Nature, and is focused on key concerns such as skin barrier health and targeted solutions that address sun and wind exposure, pollution and heat, and sweat, all well preserving the balance of the skin microbiome.
“My entire career I've been looking for products that are engineered for performance and built for me as a professional athlete, but that are not detrimental to my body or the planet,” says Slater. “With Freaks of Nature, we've finally cracked that code, enabling athletes to go harder at their sport for longer.”
The Deeper Dive Moisturizer ($48) comprises a post-biotic Bacillus ferment to provide prebiotic support to the skin microbiome and brown algae extract to boost collagen and hydrate the skin.
Per MyMicrobiome, “Some sunscreens may disrupt this delicate microbial balancec, potentially leading to skin issues such as inflammation and irritation. Therefore, the formulation of microbiome-friendly sunscreens is becoming increasingly important.”
(The moisturizer's microbiome claims were validated with the HelloBiome platform.)
The moisturizer also highlights “bio-fabricated” squalane, which is also featured in the brand's sunscreen.
The Daily Defender Sunscreen ($35), meanwhile, delivers SPF 30 defense with 18% non-nano zinc oxide. As such, it is reportedly reef-safe and compliant with Hawaii's reef act 104.
The formulation comprises Bolt Threads' B-silk biobased and vegan polypeptide, which acts as a reportedly superior alternative to silicone elastomers.
The polypeptide acts as a biodegradable film former to render products silky soft on the skin while providing a barrier against pollution, blue light and even UV, per Bolt Threads.
The technology helps support 40-minute water resistance for the formulation.
“The outdoor athlete is the ultimate embodiment of what we call at Squared Circles the Conscious Maximalist consumer,” says Lukas Derksen, co-founder of Squared Circles. “A highly discerning audience who will refuse to compromise on product performance or sustaining the planet. Freaks of Nature clearly delivers on both.”
Water-based SPF Defense is on the Rise
A May 2024 SPF trend report from Spate and Symrise noted that searches for water-based sunscreens have spiked 243.6% year-over-year, reflecting consumer desires for fluid and transparent textures in their UV defense products.
 A May 2024 SPF trend report from Spate and Symrise noted that searches for water-based sunscreens have spiked 243.6% year-over-year, reflecting consumer desires for fluid and transparent textures in their UV defense products.Anna at Adobe Stock
A May 2024 SPF trend report from Spate and Symrise noted that searches for water-based sunscreens have spiked 243.6% year-over-year, reflecting consumer desires for fluid and transparent textures in their UV defense products.Anna at Adobe Stock
SPD-WT1 offers sensorial benefits and SPF properties in addition to its environmentally friendly profile by using water instead of organic or synthetic solvents—notably for sun care applications.
The technology provides high transparency and fluidity to formulations and, as a low viscosity dispersion, it is reportedly easy to mix into water.
Notably, the technology is also waterproof but easy to wash away.
Key features of the ingredient include:
- Aqueous dispersion of hydrophobic treated ultrafine TiO2 that can be added to the water phase.
- High concentration TiO2 dispersion making it easy to create high SPF products.
- Achieves both water resistance and washability with soap
- Low viscosity and easy-to-use
- ISO 16128/Natural Origin Index (NOI): 76.5%
According to the supplier's head of sales/cosmetics, Martin Kropfgans, Ph.D., “If you have a water-based formulation, you might assume it is not water resistant—but we have data showing that it is. The data was the result of a test, where we applied each dispersion to synthetic leather and water resistance as well as washability were evaluated. As a conclusion, while being water resistant, it’s quite easily removable if you use soap—whereas other water-based formulations were not water resistant.”
Simplified SPF: Doing More with Less
 Amid a general push in beauty toward simpler, more multifunctional formulas, as well as demands for reef-safe SPF products, emerging technologies offer brands an opportunity to deliver defense with higher efficiency and lower costs.soft_light at Adobe Stock
Amid a general push in beauty toward simpler, more multifunctional formulas, as well as demands for reef-safe SPF products, emerging technologies offer brands an opportunity to deliver defense with higher efficiency and lower costs.soft_light at Adobe Stock
For instance, Sharon Personal Care’s Capsol multifunctional sun care encapsulation and delivery system (INCI: Carthamus tinctorius (safflower) oleosomes, aqua) reportedly allows brands to cut their formulations’ organic actives loads by as much as 50-80% without any degradation of SPF defense.
In effect, the hydro-soluble liquid technology, which has emulsifier properties, can boost environmental safety and sustainability while reducing formulation costs.
Furthermore, Capsol’s oleosin protein, phospholipid membrane and triacylglycerol component content nourishes the skin, per Sharon Personal Care. The technology thereby reportedly offers a “superior” skin feel. It also supports water resistance without the need for additional film formers.
Capsol is therefore recommended for applications such as daily wear SPF moisturizers, beachwear sunscreens, daily wear SPF color cosmetics and anti-aging skin care applications.
Lubrizol’s recent sun care concept collection also tapped multifunctionality with its Age Defense Eco-friendly 1 SPF 50+ organic sunscreen.
The fluid sunscreen featured a “good ecological profile,” per the company, and a light sensory experience. The formulation also notably minimized the signs of aging and provided exposome protection.
Another concept in the Lubrizol collection, the Whipped Matte Sunscreen SPF 50, offered a soft and fluffy oil-in-water sunscreen that delivers SPF defense while reducing sebum levels and minimizing the appearance of pores. The whipped-cream-like formulation goes on without white cast, per the company, and offers a “luxurious matte finish.”
Free-from Sun Care That Works
The previously cited Symrise x Spate report found that mineral sunscreen searches have jumped 27.3% year-over-year. At the same time, searches for zinc and titanium dioxide sunscreens are up 18.5% and 20.2%, respectively, year-over-year.
Clearly, interest in non-chemical sunscreens is on the upswing. But so too are ingredient concerns.
In response, cosmetics manufacturer Sun Deep has developed a sustainable non-chemical sunscreen that manages to satisfy a number of requirements.
The company’s latest formulation features plant-derived UV boosters, preservatives and film formers while delivering SPF 30 defense with 80-minute water resistance.
All of this was achieved with no silicone, per Sun Deep.
When the Damage is Done: UV Solutions
 Recently, Kiehl's launched the Auto-Tone Discoloration & UV Solution SPF 30 treatment, which reportedly helps to “correct discoloration without shifting skin's natural tone, while helping to prevent future discolorations.”Kiehl's
Recently, Kiehl's launched the Auto-Tone Discoloration & UV Solution SPF 30 treatment, which reportedly helps to “correct discoloration without shifting skin's natural tone, while helping to prevent future discolorations.”Kiehl's
The treatment comprises parent company L’Oréal’s Melasyl, a molecule designedd to address localized pigmentation issues that lead to age spots and post-acne marks.
L’Oréal formulations containing the proprietary ingredient work inclusively, across all skin tones, to address pigmented marks on the skin and improve their appearance.
The underlying technology was reportedly validated in a number of studies. One randomized controlled clinical study noted that Melasyl, known as 2-mercaptonicotinoyl glycine (2-MNG), “inhibited both UV-induced skin pigmentation mechanisms in vivo. The association of 2-MNG with LHA plus MSX showed the highest efficacy on melanin-rich skin with pigmentation induced by UV exposure.”
The treatment, which retails for $52, provides SPF 30 defense against future UV damage while tapping Melasyl to homogenize areas of excess melanin to even out the skin tone.
The multifunctional formulation can simultaneously address post-blemish marks, dark spots, dark patches and uneven tone, per Kiehl’s.
Countering UV Damage: Hyperpigmentation & Premature Aging
While prevention is the best policy when it comes to UV damage, there are a host of ingredient technologies to address the aesthetic impacts once any damage is done.
Recently, the Center for Drug Design at the University of Minnesota’s College of Pharmacy highlighted the benefits of a novel ingredient, ProteXidine, a bomimetic antioxidant technology that reportedly counteracts UV skin damage while inhibiting further damage caused by reactive oxygen species (ROS).
The technology can also reportedly reduce and clear away cyclobutene pyrimidine dimers (CPDs), which are associated with UV-induced mutations that can lead to skin cancers.
Human ex vivo skin culture studies purportedly showed that ProteXidine significantly limited the formation of CPDs in UV-irradiated cultures after 4 hours; after 12 hours, virtually no CPDs were detected in the cultures.
Furthermore, ProteXidine’s ability to clear away damaged epidermal cells induces their replacement with healthy cells, per University of Minnesota researchers.
The technology has the potential to maintain the epidermal layer and collagen density in UV-exposed skin, based on results from the skin culture studies.
Based on the current evidence, the researchers recommend ProteXidine for application in anti-aging skin care, hyperpigmentation solutions, anti-photoaging solutions and moisturization boosters.
Quickly Reducing UV-induced Inflammation
 BASF’s Hydrasensyl Glucan Green (INCI: water (aqua) (and) beta-glucan) reportedly merges beneficial properties of hyaluronic acid and collagen to quickly soothe UV-induced erythema, per the company.Sendo at Adobe Stock
BASF’s Hydrasensyl Glucan Green (INCI: water (aqua) (and) beta-glucan) reportedly merges beneficial properties of hyaluronic acid and collagen to quickly soothe UV-induced erythema, per the company.Sendo at Adobe Stock
The ingredient’s primary structure in part consists of a long chain of disaccharide units made of two glucose derivatives. This structure enables Hydrasensyl Glucan to bind large amounts of water in the skin, like a natural water-superabsorber, per the company.
The polysaccharide chains of the ingredient are intertwined to form a rope-like, highly resilient triple-helix like collagen. This 3D structure makes it highly stable and resilient under harsh formulation conditions.
The technology quickly soothes UV-induced erythema, while also offering skin smoothing and hydrating properties, per the company.
In vitro studies reportedly showed a reduction of UV-induced erythema, short-term and long-term sustainable hydration, and short-term and long-term sustainable skin smoothness.
In vivo studies displayed a reduction of pro-inflammatory mediators, activation of surveillance receptor TLR-2 and protection of circadian gene from blue light.
The beta-glucan active ingredient offers multifunctional claims for applications such as after-sun, face, body and hand care, per BASF.
Efficacy is a Must: Clinicals for Sun-inspired Beauty
In an era of consumer demands for efficacy, getting clinical testing right is critical. Especially for OTC products.Shawn Hempel at Adobe Stock
In an era of consumer demands for efficacy, getting clinical testing right is critical. Especially for OTC products.Shawn Hempel at Adobe Stock
“Brands are seeking more holistic environmental protection claims, combining protection from UV with protection against blue light, ozone and pollution,” says Matt Traynor, Ph.D., innovation and validation director, Certified Laboratories. “Daily SPF products are also expected to provide additional benefits such as reduction of fine lines and wrinkles as well as evening skin tone and brightening.”
Traynor warns, “Brands need to ensure that any SPF products meet stability/compatibility requirements for OTCs. This ensures effectiveness of sunscreens over the lifetime of the product.”
There are a number of claims pitfalls brands need to keep in mind when approaching their SPF and other claims.
“Brands must adhere to good clinical practices (GCP) with third party vendors to appropriately support their claims,” says Traynor. “Brands must be careful. They cannot solely rely on testimonials or consumer perceptions for sufficient support.”
Traynor adds, “Brands must also clearly state whether a claim supports the product performance or an ingredient benefit. Products must be manufactured in accordance with good manufacturing practice (GMP) and tested prior to release in the FDA registered GMP compliant testing facility.”
But what about timelines?
Clinical and consumer studies can take 3-6 months to complete, per Traynor, though in vitro ingredient claim support studies can be accomplished much faster. At the same time, microbiology testing and chemical ingredient assays for batch release requirements can be accomplished in 5 business days or fewer.
Trouble Ahead: Sun Care’s Misinformation Problem
 According to a 2024 Ipsos/Orlando Health Cancer Institute study, 32% of Americans believe that tans make “people look better and healthier.”Trendsetter Images at Adobe Stock
According to a 2024 Ipsos/Orlando Health Cancer Institute study, 32% of Americans believe that tans make “people look better and healthier.”Trendsetter Images at Adobe Stock
Sun care is indispensable, but it has a misinformation problem. Solving this issue will allow brands to tap into an even wider section of the consumer base.
According to a 2024 Ipsos/Orlando Health Cancer Institute study, 32% of Americans believe that tans make “people look better and healthier.”
Just as concerning, 14% of adults under 35 claim “daily sunscreen use is more harmful to the skin than direct sun exposure,” per the institute, while 23% “believe drinking water and staying hydrated prevent a sunburn.”
Counteracting these beliefs will require robust educational strategies from brands, particularly on social platforms such as TikTok, while also developing products that are easily incorporated into daily beauty rituals.
Putting Insights Into Action: Sun-kissed Beauty Contract Manufacturing
 FP Labs is developing a line of stock formulas with SPF, including its Clear SPF 30, which helps brands get to market faster without incurring excess lab time. In most cases, FP Labs can change fragrance with little to no reformulation.FP Labs
FP Labs is developing a line of stock formulas with SPF, including its Clear SPF 30, which helps brands get to market faster without incurring excess lab time. In most cases, FP Labs can change fragrance with little to no reformulation.FP Labs
This includes lotions that moisturize and hydrate, as well as protect, featuring high-performance ingredients like salicylic acid, hyaluronic acid, and vitamins D and E, to join SPF ingredients to meet that demand.
FP Labs' R&D and chemistry teams work directly with customers based on their specific performance requirements, whether in a lotion or serum. The manufacturer's team is well-versed in SPF ingredients as well as new zinc technology that reduces white cast, a is common challenge with increasingly popular mineral SPFs.
FP Labs is also developing a line of stock formulas with SPF, including its Clear SPF 30, which helps brands get to market faster without incurring excess lab time. In most cases, FP Labs can change fragrance with little to no reformulation.
FOOTNOTES
awww.prnewswire.com/news-releases/study-uncovers-growing-sunxiety-and-demand-for-multi-functional-sunscreen-302187269.html
bhttps://blog.trendalytics.co/summer-suncare-trends
cwww.linkedin.com/feed/update/urn:li:activity:7213538708417875969/
dwww.gcimagazine.com/ingredients/skin-care/news/22889809/la-rocheposay-the-science-behind-lorals-melasyl-pigmentation-technology
ehttps://drugdesign.umn.edu/protexidinetm-functional-cosmetic-enhancing-skin-appearance











